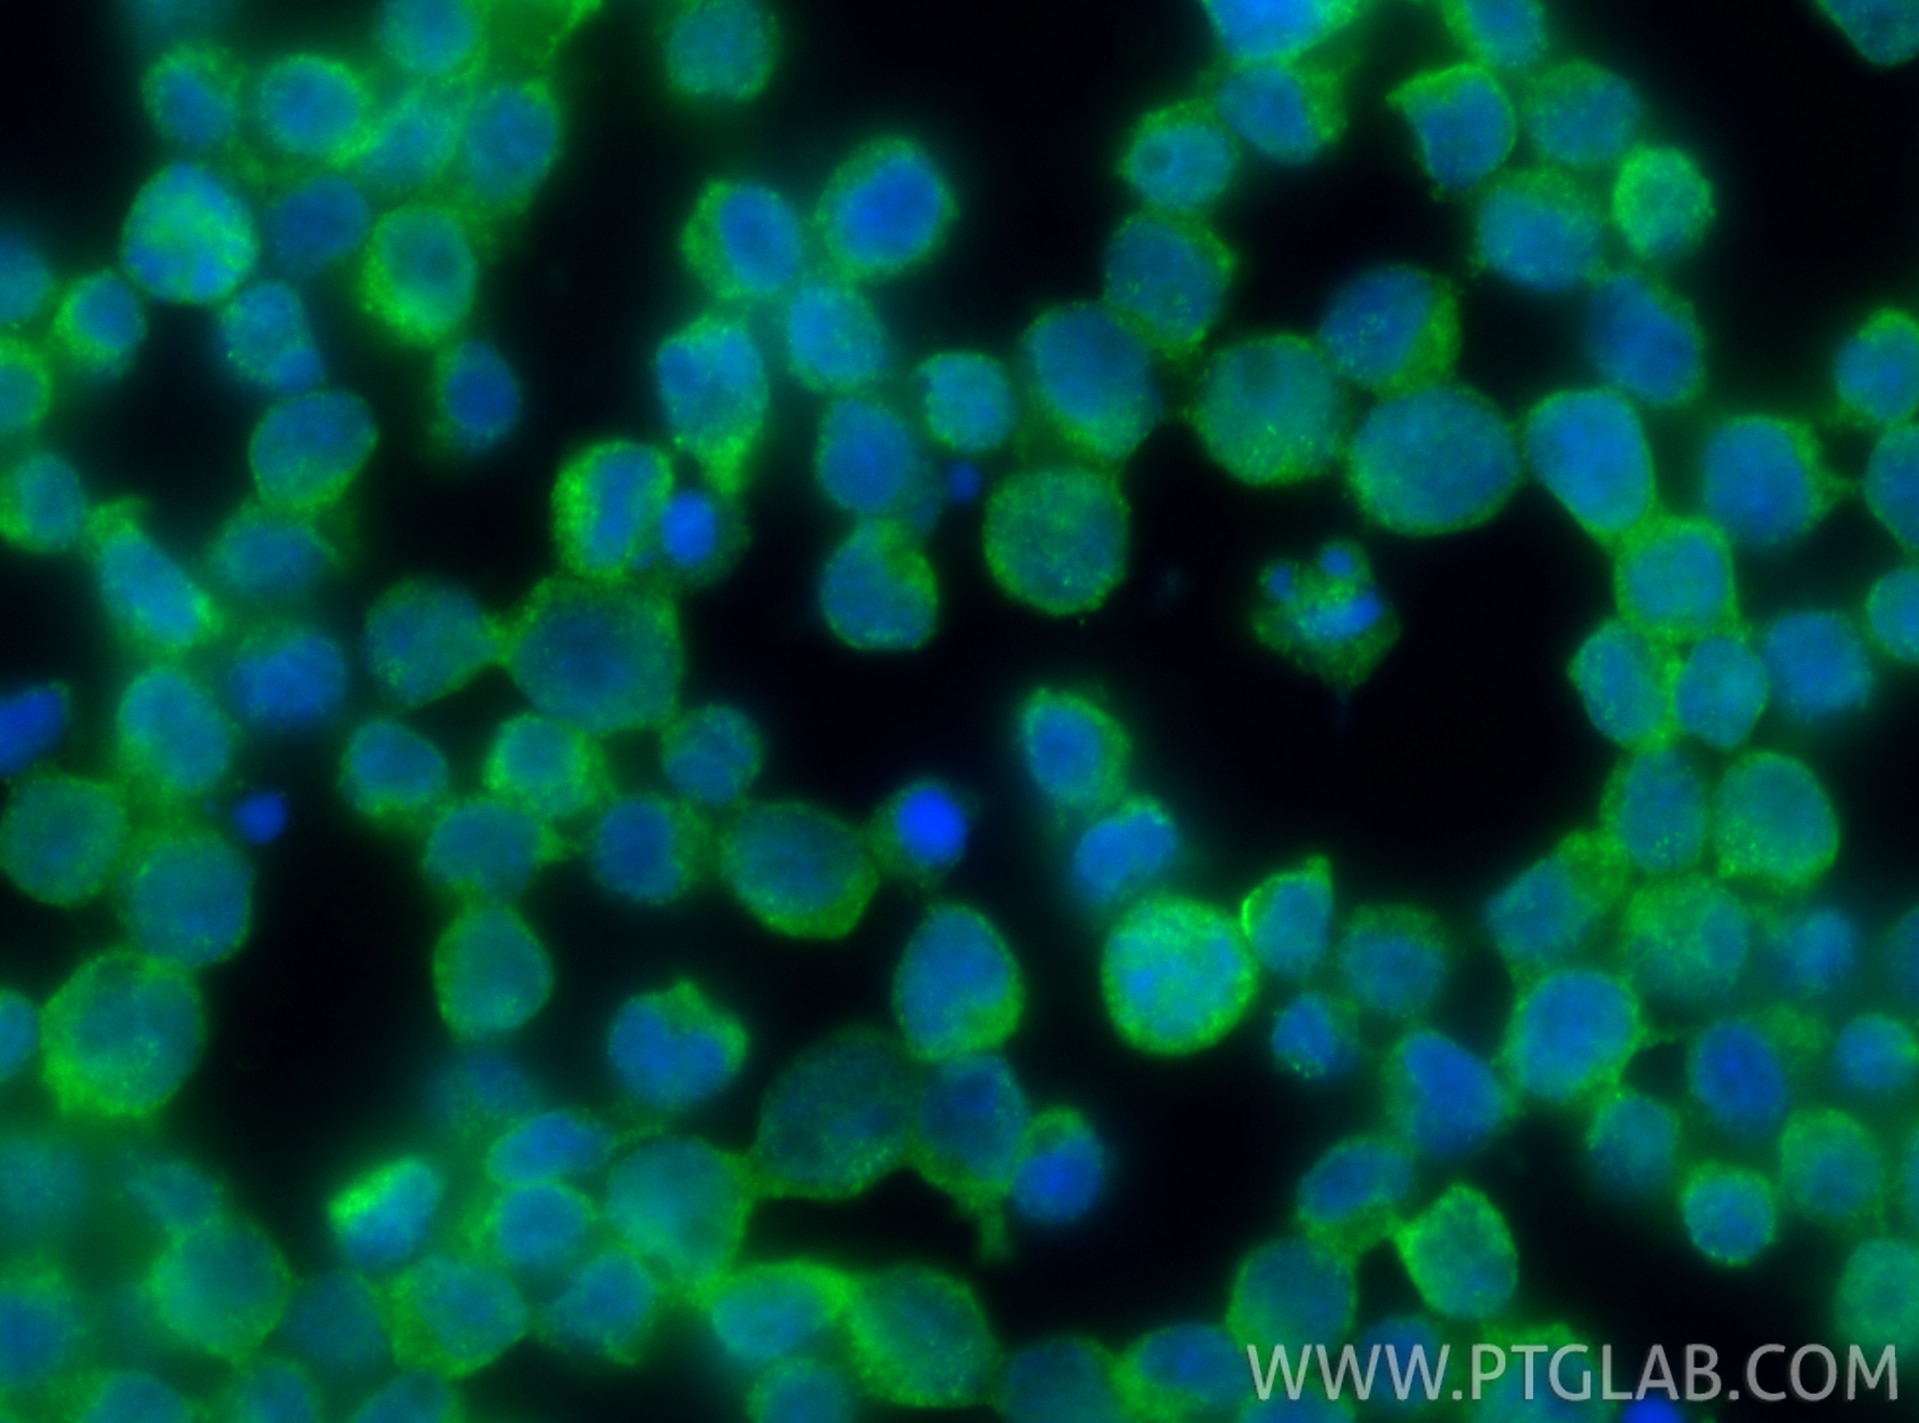

Tested Applications
| Positive WB detected in | HL-60 cells |
| Positive IHC detected in | human lymphoma tissue, mouse spleen tissue Note: suggested antigen retrieval with TE buffer pH 9.0; (*) Alternatively, antigen retrieval may be performed with citrate buffer pH 6.0 |
| Positive IF-P detected in | mouse spleen tissue |
| Positive IF/ICC detected in | MCF-7 cells, Jurkat cells |
Recommended dilution
| Application | Dilution |
|---|---|
| Western Blot (WB) | WB : 1:500-1:2000 |
| Immunohistochemistry (IHC) | IHC : 1:50-1:500 |
| Immunofluorescence (IF)-P | IF-P : 1:50-1:500 |
| Immunofluorescence (IF)/ICC | IF/ICC : 1:200-1:800 |
| It is recommended that this reagent should be titrated in each testing system to obtain optimal results. | |
| Sample-dependent, Check data in validation data gallery. | |
Published Applications
| KD/KO | See 1 publications below |
| WB | See 11 publications below |
| IHC | See 29 publications below |
| IF | See 13 publications below |
Product Information
13588-1-AP targets Granzyme B in WB, IHC, IF/ICC, IF-P, ELISA applications and shows reactivity with human, mouse samples.
| Tested Reactivity | human, mouse |
| Cited Reactivity | human, mouse, rat |
| Host / Isotype | Rabbit / IgG |
| Class | Polyclonal |
| Type | Antibody |
| Immunogen |
CatNo: Ag3883 Product name: Recombinant human GZMB protein Source: e coli.-derived, PGEX-4T Tag: GST Domain: 1-247 aa of BC030195 Sequence: MQPILLLLAFLLLPRADAGEIIGGHEAKPHSRPYMAYLMIWDQKSLKRCGGFLIQDDFVLTAAHCWGSSINVTLGAHNIKEQEPTQQFIPVKRPIPHPAYNPKNFSNDIMLLQLERKAKRTRAVQPLRLPSNKAQVKPGQTCSVAGWGQTAPLGKHSHTLQEVKMTVQEDRKCESDLRHYYDSTIELCVGDPEIKKTSFKGDSGGPLVCNKVAQGIVSYGRNNGMPPRACTKVSSFVHWIKKTMKRH Predict reactive species |
| Full Name | granzyme B (granzyme 2, cytotoxic T-lymphocyte-associated serine esterase 1) |
| Calculated Molecular Weight | 247 aa, 28 kDa |
| Observed Molecular Weight | 33 kDa |
| GenBank Accession Number | BC030195 |
| Gene Symbol | Granzyme B |
| Gene ID (NCBI) | 3002 |
| RRID | AB_2114429 |
| Conjugate | Unconjugated |
| Form | Liquid |
| Purification Method | Antigen affinity purification |
| UNIPROT ID | P10144 |
| Storage Buffer | PBS with 0.02% sodium azide and 50% glycerol, pH 7.3. |
| Storage Conditions | Store at -20°C. Stable for one year after shipment. Aliquoting is unnecessary for -20oC storage. 20ul sizes contain 0.1% BSA. |
Background Information
GZMB(Granzyme B) is also named as CGL1, CSPB, CTLA1, GRB and belongs to the Granzyme subfamily. This enzyme is necessary for target cell lysis in cell-mediated immune responses. The cytotoxic lymphocyte protease granzyme B (GzmB) can promote apoptosis through direct processing and activation of members of the caspase family. GzmB can also cleave the BH3-only protein, BID, to promote caspase-independent mitochondrial permeabilization (PMID:17283187). GzmB induces laminB degradation in isolated nuclei less efficiently than GzmA (PMID:11331782). This full length protein has 2 glycosylation sites and a signal peptide. Unglycosylated human granzyme B is 26 kDa and high mannose glycosylated is 32 kDa and only 32kDa or smaller forms of granzyme B are accumulated within nuclei (PMID:8626751). GzmB also forms dimers.
Protocols
| Product Specific Protocols | |
|---|---|
| IF protocol for Granzyme B antibody 13588-1-AP | Download protocol |
| IHC protocol for Granzyme B antibody 13588-1-AP | Download protocol |
| WB protocol for Granzyme B antibody 13588-1-AP | Download protocol |
| Standard Protocols | |
|---|---|
| Click here to view our Standard Protocols |
Publications
| Species | Application | Title |
|---|---|---|
J Am Acad Dermatol Generalized bullous fixed drug eruption is distinct from Stevens-Johnson syndrome/toxic epidermal necrolysis by immunohistopathological features. | ||
Biomaterials In situ subcutaneously injectable thermosensitive PEG-PLGA diblock and PLGA-PEG-PLGA triblock copolymer composite as sustained delivery of bispecific anti-CD3 scFv T-cell/anti-EGFR Fab Engager (BiTEE). | ||
J Nanobiotechnology Oxygen-delivery nanoparticles enhanced immunotherapy efficacy monitored by granzyme B PET imaging in malignant tumors | ||
Oncogene B7-H4 is increased in lung adenocarcinoma harboring EGFR-activating mutations and contributes to immunosuppression. | ||
Clin Transl Med c-Myb facilitates immune escape of esophageal adenocarcinoma cells through the miR-145-5p/SPOP/PD-L1 axis. |